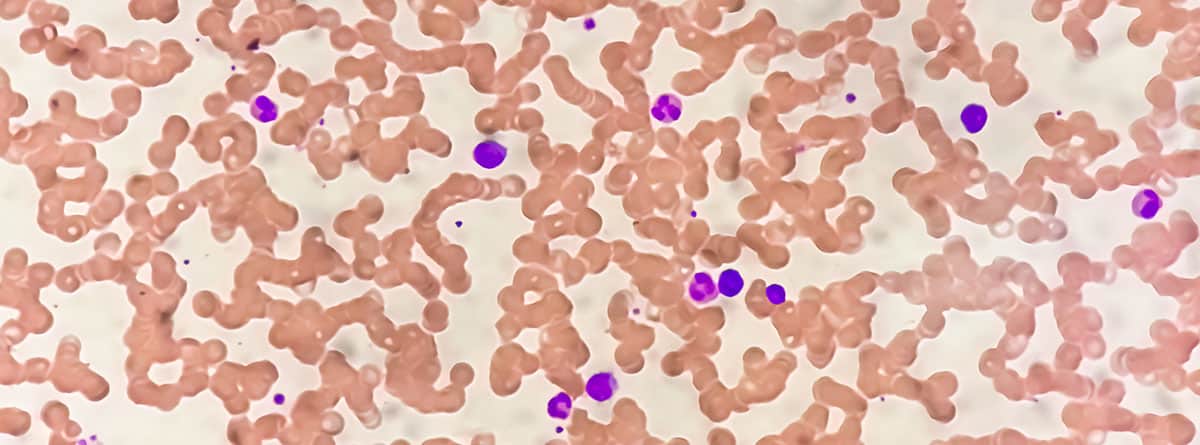

Los monocitos son un tipo de glóbulos blancos (leucocitos) que, como todas las células de la sangre, se fabrican en la médula ósea. Los monocitos viajan por la sangre hasta los tejidos del cuerpo, donde se convierten en macrófagos o células dendríticas y contribuyen a la eliminación de microorganismos, material extraño o células muertas y estimulan la respuestas inmunitaria.
El recuento de los leucocitos, de glóbulos rojos (hematíes) y de plaquetas, que constituyen las tres series sanguíneas, es lo que se conoce como “hemograma” y se estudia a través de un análisis de sangre.
En el hemograma se refleja el recuento total de leucocitos en la sangre (valores normales de 4500 a 11000/mm3) y la fórmula leucocitaria que expresa el porcentaje y el número absoluto de cada uno de los tipos de glóbulos blancos presentes en sangre periférica teniendo en cuenta que los valores de normalidad pueden variar ligeramente entre cada laboratorio.
- Neutrófilos: 54-62%
- Linfocitos: 25-33%.
- Monocitos: 3-7%
- Eosinófilos: 1-3%
- Basófilos: 0-1%
El valor normal en números absolutos de monocitos oscila entre ente 200 y 800 por mm3 con valores que pueden variar en función de la edad y el sexo. Hablamos de monocitosis en valores absolutos cuando los monocitos superan los 900 por mm3.
Causas de monocitosis
En la inmensa mayoría de casos el aumento de monocitos se produce de manera reactiva es decir no es una enfermedad sino que se produce como respuesta de la médula ósea a una causa subyacente
Causas de monocitosis reactiva
- Inducida por el ejercicio
- Estrés
- Infecciones: leptospirosis, listeriosis, paludismo, tuberculosis, brucelosis, leishmaniasis, sífilis, rickettsiosis…
- Tras la extirpación del bazo
- Enfermedades inflamatorias o autoinmunes: sarcoidosis, colitis ulcerosa, artritis reumatoide …
- Infarto de miocardio
- En la fase de recuperación de la médula ósea tras quimioterapia
- Fármacos: Corticoides…
- Tumores sólidos

Tratamiento
La “monocitosis reactiva” no requiere de ningún tratamiento. Al detectarla lo que hay que hacer es ver si se produce por una enfermedad subyacente y tratar esta enfermedad si es el caso.
Una monocitosis puntual que ya no se detecta al realizar un hemograma de control es menos preocupante que una monocitosis que persiste en el tiempo.
Monocitosis asociadas a enfermedades hematológicas
En algunos casos la monocitosis se asocia a una enfermedad hematológica. En estos casos el resto de los parámetros del hemograma suelen presentar alteraciones en el recuento de glóbulos rojos y/o de plaquetas, lo que motiva la derivación del paciente al especialista en Hematología.
La enfermedad hematológica que sobre todo entra en el diagnóstico diferencial en adultos ante una monocitosis (monocitos de ≥1000 por mm3 ≥10% en la fórmula leucocitaria) persistente (>3 meses) es la leucemia mielomonocítica crónica.
Diagnóstico
El diagnóstico de esta enfermedad requiere estudiar la morfología de las células sanguíneas al microscopio realizando un frotis de sangre periférica y un aspirado o biopsia de médula ósea. La presencia de una alteración en la cifra de hematíes y/o plaquetas, el aumento del tamaño del bazo o del hígado, o la presencia de fatiga, sudoración nocturna, dolores óseos o pérdida de peso pueden orientar hacia el diagnóstico de esta enfermedad. En niños, la leucemia mielomonocítica juvenil es una enfermedad hematológica poco frecuente.
Lo que debes saber…
- Hablamos de monocitosis en valores absolutos cuando los monocitos superan los 900 por mm3.
- En la inmensa mayoría de casos el aumento de monocitos se produce de manera reactiva es decir no es una enfermedad sino que se produce como respuesta de la médula ósea a una causa subyacente.
- En algunos casos la monocitosis se asocia a una enfermedad hematológica. En estos casos el resto de los parámetros del hemograma suelen presentar alteraciones en el recuento de glóbulos rojos y/o de plaquetas, lo que motiva la derivación del paciente al especialista en Hematología.
Bibliografía
- Mangaonkar AA, Tande AJ, Bekele DI. Differential Diagnosis and Workup of Monocytosis: A Systematic Approach to a Common Hematologic Finding. Curr Hematol Malig Rep. 2021 Jun;16(3):267-275.
- Patnaik MM, Tefferi A. Chronic myelomonocytic leukemia: 2022 update on diagnosis, risk stratification, and management. Am J Hematol. 2022 Mar 1;97(3):352-372.
- Gupta AK, Meena JP, Chopra A, Tanwar P, Seth R. Juvenile myelomonocytic leukemia-A comprehensive review and recent advances in management. Am J Blood Res. 2021